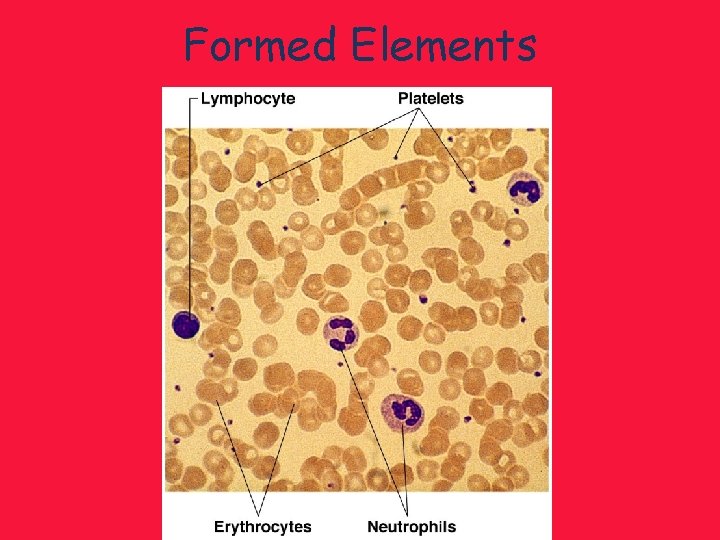
Formed Elements

Chapters 10 11 Blood The Cardiovascular System Blood

Chapters 10 & 11: Blood & The Cardiovascular System

Blood Composition

Blood • The only fluid tissue • Connective tissue • Components of blood – Living cells • Formed elements – Non-living matrix • Plasma

Components • 45% =erythrocytes (red blood cells) • Less than 1%= leukocytes (white blood cells) and platelets • 55% = plasma

Characteristics • Color range – Oxygen-rich blood = bright red – Oxygen-poor blood = dull red • • p. H = 7. 35– 7. 45 (slightly basic) Blood temperature = 100. 4°F Volume = 5– 6 liters Makes up 8% of body weight

Blood Plasma • 90% water • 10% dissolved substances – Nutrients – Salts (electrolytes) – Respiratory gases – Hormones – Plasma proteins – Waste products

• Plasma proteins – Most abundant solutes in plasma – Made by liver – Examples: • Albumin—osmotic balance; p. H buffering • Clotting proteins—prevents blood loss when a blood vessel is injured • Antibodies—protects from pathogens

• Acidosis – Blood becomes too acidic • Alkalosis – Blood becomes too basic • In each scenario, the respiratory system and kidneys help restore blood p. H to normal
Formed Elements

Erythrocytes • Red blood cells (RBCs) – Biconcave disks – No nucleus – Very few organelles – Large surface for gas exchange • Carry oxygen • Outnumber WBCs by 1000 to 1 • About 5 million per mm 3 • Contains hemoglobin – Iron-containing protein – Binds strongly, but reversibly, to oxygen – Each hemoglobin molecule has four oxygen binding sites – 1 RBC = 1 billion oxygen molecules

Leukocytes • White blood cells (WBCs) • Body’s defense against disease • Only complete cells in blood, with a nucleus and organelles • Able to move into and out of blood vessels (= diapedesis) http: //www. youtube. com/watch? v=uo. Sw. Li_CVXs • Can respond to chemicals released by damaged tissues (= chemotaxis) http: //www. youtube. com/watch? v=Kx. TYy. NEb. VU 4&feature=related • Increase in number during infection • 2 kinds: – Granulocytes (particles in cytoplasm can be stained and then seen) – Agranulocytes (no particles)

Platelets • Fragments of multinucleate cells (= megakaryocytes) • Needed for the clotting process

Blood Disorders • Anemia = decrease in the oxygencarrying ability of the blood – May be caused by low iron diet = tiredness • Sickle cell anemia (SCA) = genetic disorder resulting in abnormally shaped hemoglobin • Leukocytosis = high WBC count, indicating an infection • Leukopenia = low WBC count, caused by drugs like anticancer meds • Leukemia = cancer of bone marrow, makes excess WBCs

Figure 10. 3

Hematopoiesis & Hemostasis

Hematopoiesis • Blood cell formation • Occurs in red bone marrow – Inside most bones in children – Only in flat bones and epiphysis of humerus & femur in adults • Makes ~100 billion cells (1 oz) per day

• All blood cells are derived from a common stem cell (hemocytoblast) • Hemocytoblast then differentiates (forms specialized jobs) into either: – Lymphoid stem cell: produces lymphocytes – Myeloid stem cell: produces all other formed elements

Figure 10. 4

Formation of Erythrocytes • Unable to divide, grow, or make proteins • Live 100 -120 days • When worn out, RBCs are eliminated by phagocytes in the spleen or liver • Lost cells are constantly replaced

Hormonal Regulation • RBC production is controlled by erythropoietin – Made by kidneys when oxygen levels in blood are too low – Negative feedback mechanism • WBC production controlled by colony stimulating factors (CSFs) and interleukins • Platelet production controlled by thrombopoietin

Imb ala nce Stimulus: Decreased RBC count, decreased availability of O 2 to blood, or increased tissue demands for O 2 Normal blood oxygen levels Imb ala nce Increased O 2 - carrying ability of blood Reduced O 2 levels in blood More RBCs Kidney releases erythropoietin Enhanced erythropoiesis Erythropoietin stimulates Red bone marrow Figure 10. 5

Hemostasis • Stoppage of bleeding resulting from a break in a blood vessel • Hemostasis involves three phases 1. Vascular spasms: narrowing of vessels to limit blood loss 2. Platelet plug formation: once vessels are damaged, platelets cling to that area 3. Coagulation : blood clotting

• Takes 3 -6 minutes • Sterile gauze speeds up clotting time because more places for platelets to hold on

Clotting Disorders. Too Much Clotting • Thrombus – A clot in an unbroken blood vessel – Can block blood flow esp around heart – May result in heart attack • Embolus – A thrombus that breaks away and floats freely in the bloodstream – Can later clog vessels in critical areas such as the brain – May result in a stroke http: //www. youtube. com/watch? v=Ai. C 1 V 5 z. Aba 4&feature=related

Not Enough Clotting • Thrombocytopenia – Platelet deficiency – Even normal movements can cause bleeding – Creates purple blotches on skin – Treated by vit K supplements or transfusions • Hemophilia – Hereditary bleeding disorder – Normal clotting factors are missing – Minor trauma = major bleeding – Treated by tranfusion of plasma or injection of missing clotting factor

Human Blood Types

Transfusions • Body can lose 15– 30% of blood and still compensate; causes weakness • Loss of over 30% causes shock, which can be fatal • Transfusions are the only way to replace blood quickly • Transfused blood must be of the same blood group

Human Blood Groups Antigens • • Surface proteins found on blood cell Act as ID tags Genetic Used to recognize foreign cells

Antibodies • Blood proteins that recognize antigens • Each antibody is specific to one antigen • Binding of blood antigens and antibodies result in clumping (=agglutination) – Causes blocked vessels and kidneys – Blood cells with foreign antigens are destroyed so tissues don’t get oxygen

• Type A ABO Blood Groups – A antigens on surface – Forms anti-B antibodies @ infancy • Type B – B antigens on surface – Forms anti-A antibodies @ infancy • Type AB – A and B antigens on surface – No antibodies are formed • Type O – No antigens on surface – Forms anti-A and anti-B antibodies @ infancy


• Blood type A can receive A and O blood • Blood type B can receive B and O blood • Blood type AB can receive A, B, AB, and O blood – Universal recipient • Blood type O can only receive O blood – Universal donor


Table 10. 3

Rh Blood Groups • Named for Rhesus monkey that has the same antigen • Humans are either Rh+ (have the antigen) or Rh- (do not have the antigen) • Most Americans are Rh+ • Problems can occur in mixing Rh+ blood into a body with Rh– blood

Rh Dangers During Pregnancy • Danger occurs only when the mother is Rh– and the child is Rh+ – Mother forms antibodies – 1 st pregnancy is OK, no time to attack – 2 nd pregnancy mom’s antibodies attack; requires fetal blood transfusion • Rho. GAM shot can prevent buildup of anti-Rh+ antibodies in mother’s blood

Blood Typing • Process used to determine ABO group of a person • Person’s blood samples are mixed with anti -A and anti-B serum • If coagulation happens = wrong blood type

Blood Typing Figure 10. 8
- Slides: 38